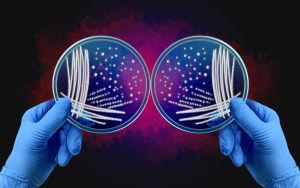

鏡の中の生命をめざして──4つの「前駆技術」が切り開く未知の合成生物学✉️35✉️
生命とは、左右どちらの手でできているのか。私たちの体をつくるアミノ酸はすべて「左手型(L型)」で統一されています。自然界のすべての生物がこの「左手の法則」に従っているのは、生命誕生の偶然から始まった「化学の非対称性(キラリティ)」によるものです。
しかし、もし右手型のアミノ酸でできたタンパク質、右手型のDNAやRNAをもつ生物を人工的に作り出すことができたら──それはもはや自然界には存在しない「鏡の中の生命」、ミラーライフ(鏡像生命体)と呼ばれる存在です。
それは、地球の生命をそのまま左右反転したもう一つの世界を生み出すことを意味します。免疫も感染も効かない、自然界のルールから逸脱した生命。多くの科学者が夢を描きながらも、その危険性を恐れる理由がここにあります。鏡像生命体の話題については、以下の記事をご覧ください。
この「鏡像生命体」への道を切り開くための鍵が、4つの技術にあります。
PUREシステム、鏡像リボソーム、クロスオーバー翻訳系、そして完全合成細胞の起動。それぞれの研究は独立して進んでいますが、重なり合うことで「鏡像生命体」という究極のゴールへと近づきつつあるのです。2025年9月、英国のマンチェスター大学で開催されたこの技術を議論する国際会議では、これらの4つの先行技術について議論されました。
今回は、これらの4つの技術について紹介してみたいと思います。
PUREシステム──試験管の中で生命を再構成する
PUREシステム(Protein synthesis Using Recombinant Elements)は、生命の最小構成を試験管の中で再現する技術です。通常、タンパク質合成は細胞の中で行われますが、PUREシステムはDNA、RNA、酵素、エネルギー分子などを純粋に組み合わせ、セルフリーで、つまり細胞を使わずにタンパク質を合成することができます。
この仕組みを「鏡像化」しようというのが、いま世界の研究者たちが挑戦している方向です。つまり、右手型のアミノ酸や右手型酵素を使って、同じ反応を再現するのです。
鏡像PUREシステムが完成すれば、鏡像タンパク質や鏡像酵素の合成が可能になります。これが意味するのは、自然界の酵素に分解されない安定な分子医薬の設計、あるいは従来の抗体が効かないウイルスへの新たな治療法など、応用の広がりです。
しかし同時に、それは「鏡像生物の基礎部品」を作ることでもあります。純粋な科学実験の積み重ねが、いつの間にか“もう一つの生命”の設計図を描くことになる。この境界をどう引くかが、PUREシステム研究の根底にある倫理的ジレンマなのです。
PUREシステムは、合成生物学の「レゴブロック」とも言われます。構成要素を自在に入れ替えることで、生命を再構成する。右手型のブロックをつくることは、レゴの世界を反転させるような試みです。いま、科学者たちはその積み木遊びがどこまで許されるのかを問われています。
鏡像リボソーム──生命の翻訳機を反転させる
生命の根幹を担う装置──それがリボソームです。リボソームはmRNAの情報を読み取り、アミノ酸をつないでタンパク質を作る“生命の翻訳機”です。
このリボソームを「鏡像化」することは、鏡像生命体の核心に迫る挑戦です。リボソームは数十種類のタンパク質とRNAが精密に組み合わさってできた巨大な分子機械であり、その構造をすべて右手型の分子で作り替えることは、まさに生命の再構築に等しい難題です。
なぜここまで注目されるのか。それは、鏡像リボソームが完成すれば、鏡像のタンパク質合成を完全自立的に行うことができるからです。つまり、「右手型の世界」で独立したタンパク質の合成が可能になる。これはもはや自然界の生命とは交わらない別のシステムです。
鏡像リボソームの研究は、分子生物学とナノテクノロジー、化学合成の融合領域で進められています。右手型のRNA断片を合成し、酵素反応を模倣する。これまで誰も見たことのない“反転した生命装置”を、分子単位で組み上げる作業です。
しかし、その道のりは決して容易ではありません。自然界のリボソームは数十億年の進化の果てに生まれた奇跡の構造です。それを人工的に再現するには、単なるコピーではなく、原理の理解そのものを反転させなければなりません。
もし成功すれば、それは科学史における「生命の鏡写し」となるでしょう。だが同時に、その成果をどこまで使うかという問いが、社会に突きつけられることになります。鏡像リボソームは、未来の治療薬を生むかもしれないし、制御不能な鏡像生物を生む可能性もあるのです。
クロスオーバー翻訳系──二つの世界をつなぐ橋
鏡像リボソームを作る前段階として、研究者たちが注目しているのが「クロスオーバー翻訳系(crossover translation systems)」です。
これは、自然界のリボソーム(左手型)を使いながら、右手型アミノ酸を組み込んで鏡像タンパク質を合成するという橋渡し技術です。言い換えれば、左手と右手の世界を同時に扱う試みです。
クロスオーバー翻訳系の難しさは、左右の分子が互いに相互作用できない点にあります。通常の酵素は右手型の基質を認識できません。したがって、右手型アミノ酸をつなぐには、リボソームの内部構造やtRNAを精密に改変しなければならない。
こうした改変を通じて、研究者たちは「左右両用の生化学反応」を設計しようとしています。これに成功すれば、鏡像生命体の完全構築を待たずして、鏡像分子の合成・解析・利用が大きく前進するでしょう。
しかし、クロスオーバー系の登場は、倫理的には複雑な影響を持ちます。なぜなら、これは「二つの世界をつなぐ」技術だからです。もし左手と右手の生命システムを融合できるなら、それは自然界の隔たりを越えた「新しい生命系」を作ることを意味します。
たとえば、右手型タンパク質を合成できる細胞を医療に応用すれば、免疫系に見つからない薬物送達が可能になります。一方で、感染や環境拡散のメカニズムが予測不能になるリスクもあります。
クロスオーバー翻訳系は、中間的な領域にあります。まだ鏡像生命体ではないが、その前段階。ここでの判断と制度設計が、将来の研究方向を大きく左右することになるのです。